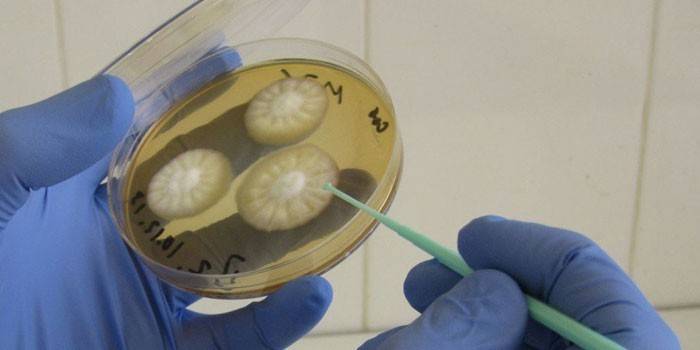
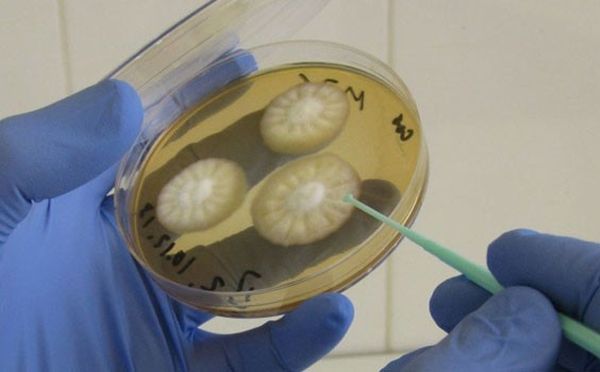

Одним из самых распространенных заболеваний у мужчин или женщин, которое протекает почти бессимптомно, считается уреаплазмоз. Чтобы определить наличие вредных микроорганизмов, вовремя назначить правильное лечение врачи берут частицу биологического материала из уретры или влагалища для исследования посева на уреаплазму. В чем особенность данного анализа? Какими должны быть результаты?
Что такое ureaplasma
На теле человека и внутри него живет миллионы различных бактерий, однако не все они являются патогенными – некоторые, напротив, полезны. Urealyticum ureaplasma – это бактерия, которая по природе происхождения относится к условно-патогенной микрофлоре. Передается этот микроорганизм от человека к человеку при использовании общих бытовых приборов, постельного белья, а также половым путем. Для его выявления делают посев на микоплазму и уреаплазму, при этом в большей части случаев обнаруживается инфицирование и анаэробными бактериями.
Бак посев на уреаплазму
Культурологический или бактериальный посев на уреаплазму – это метод лабораторного исследования, при котором у пациента берется частица биоматериала и помещается в благоприятную среду. Благодаря данному виду анализа врачи могут выявить количество вредных бактерий, степень их размножения, определить устойчивость инфекции к той или иной группе антибиотиков.
Однако в небольшом количестве уреаплазма может присутствовать в организме абсолютно здорового человека, не наносить вред. Увеличение числа патогенных бактерий происходит только при общем снижении иммунитета. Поэтому анализ назначается либо во время профилактического осмотра, либо если у врача есть подозрения инфекции. Кроме того, бакпосев следует сдавать при:
- планировании зачатия;
- подозрениях или наличии внематочной беременности;
- частой смене половых партнеров;
- протекании воспалительных процессов генитальном тракте.
Как берут анализ на уреаплазму
Если сравнить его с большинством других проб, анализ на уреаплазму не требует соблюдения жестких правил. Чтобы сдать соскоб слизистой оболочки мочеиспускательного канала для исследования пациенту следует соблюсти всего три требования:
- не заниматься сексом минимум 24 часа до назначенной даты анализа;
- гигиену половых органов пациент должен провести не позже вечера, при этом исключить использование мазей, гелей, кремов;
- последнее мочеиспускание должно быть за 3-4 часа до сдачи биоматериала.
После забора образец помещают внутрь специальной пробирки для транспортировки, а после в благоприятную для размножения бактерий среду. Бакпосев делают около трех-четырех суток, во время которых наблюдают насколько вырос уровень патогенных клеток, проводят пробы на реакцию антибиотика. После получения всех данных ставится точный диагноз, выбирается тактика лечения.
Анализ на уреаплазму у мужчин
При активном росте уреаплазмы в мужском организме может развиться ряд серьезных патологий: не гонококковый уретрит, цистит, простатит, орхит, эпидидимит. Кроме того, возбудители инфекции влияют на подвижность, количество сперматозоидов, а еще могут приводить к алегоспермии, артриту, развитию мочекаменной болезни. Анализ уреаплазма у мужчин проводится с использованием следующих материалов:
- мазка из уретры;
- секретом простаты;
- днк ПЦР;
- общий или биохимический гемотест крови;
- выделения эакулята;
- сбором мочи.
Во время сдачи микробиологического анализа следует:
- При необходимости сдачи крови утром отказаться от завтрака.
- Для выявления уреаплазмы сдавать мочу только утреннего сбора не менее 40-60 мл.
Анализ уреаплазма у женщин
Взрослые женщины заражаются уреаплазмозом через половые контакты с инфицированным партнером. Бактерии ureaplasma spp и Mycoplasma hominis приводят к вагинозу, могут стать причинами уретрального синдрома, помочь развиться эндометриту во время беременности либо после нее. Анализы на уреаплазму у женщин всегда берутся во время перерыва между менструациями.
Как берут анализ на уреаплазму у женщин:
- делают соскоб из уретры;
- внутри вагинальный мазок;
- проба слизистой с шейки матки;
- моча у женщин не исследуется.
Расшифровка анализа на уреаплазму
После трехдневного вызревания в питательной среде лаборатория дает заключение о наличии либо отсутствии инфекции. Главную роль в анализе на уреаплазму играет точный количественный критерий. В норме патогенный микроорганизмов должно быть 104 КОЕ в 1 мл жидкости. Более высокие показатели говорят о начавшемся воспалительном процессе в мочеполовом тракте.
Помимо количества лабораторным работникам необходимо определить чувствительность уреаплазменного образца на воздействие антибактериальных препаратов или антибиотиков. Благодаря такой диагностике врач может вовремя начать лечить больного и сделать правильный выбор лекарства. Однако даже после курса пропитых антибиотиков, вам все равно придется сдать анализы заново.
Цена анализа на уреаплазму
Граждане России могут получить полный спектр медицинского обслуживания, сдать необходимый посев бесплатно в любых государственных учреждениях. Однако за такую же проделанную работу при частных клиниках придется платить. Цена анализа на уреаплазму может несколько разница, но в Москве средняя стоимость такова:
Уреаплазмы — микроорганизмы, которые наделены способностью, приводить к формированию патологических процессов урогенитального тракта и органов дыхания. Они относятся к микоплазмам, поэтому не нужно удивляться, если врач назначает пройти обследование на их выявление.
Уреаплазмоз в большей части случаев имеет бессимптомное течение и не проявляется какими либо патологическими проявлениями. Особо важную роль в процессе формирования заболевания играет состояние сопротивляемости организма. Необходимо заметить, что длительное воздействие стрессовых ситуаций и перегрузки нервного и эмоционального характера также могут становиться причиной формирования болезни.
Особую опасность представляет заболевание для женщин в период вынашивания ребенка, ведь может произойти инфицирование околоплодных вод и плода, поэтому очень важно проводить исследование на уреаплазмоз. В арсенале медицинских работников современности является немалое количество методов диагностики уреаплазмоза. Самым простым и дешевым считается бак посев на уреаплазму. О том, что же представляет собой анализ, и какие результаты можно получить путем его проведения, мы поговорим в представленной статье более детально.
Характеристика метода обследования
Прежде всего, необходимо акцентировать внимание на том, что посев на уреаплазму и микоплазму не назначается лицам при отсутствии у них симптомов процесса воспаления и инфекции половых путей. В основе проведения исследования лежит осуществление обследования биологического материала, взятого из мочеполовых путей.
После забора обследуемый материал отправляют в транспортную среду и только потом на питательную. Располагается он там, на протяжении семидесяти двух часов. Бактериологический посев помогает определить численность микроорганизмов и их титр по отношению к другим болезнетворным бактериям.
Посев осуществляют на жидкие и твердые среды, выращенная культура за своим внешним видом напоминает жареное яйцо. Самым результативным считается проведение бакпосева на уреаплазму на агаровую среду с мочевиной. Бактерии будут расти в виде колоний незначительных размеров темно-коричневого окраса.
Показания к проведению обследования
С тем, что такое посев мы разобрались, а теперь выясним, при каких состояниях он проводится. Проходить обследование на уреаплазму рекомендуется лицам:
- результаты мазка на микрофлору которых показали процесс воспалительного характера, локализующийся в уретре, влагалище или на шейке матки, и при этом причина его формирования остается неизвестной;
- с наличием часто повторяющихся обострений бактериального вагиноза;
- обследование половых партнеров, которых показало наличие генитальной микоплазмы;
- часто меняющим половых партнеров и не использующим барьерных средства защиты;
- планирующим беременность;
- женщинам в период вынашивания ребенка с развитием осложнений;
- которым будет проведено оперативное вмешательство или манипуляции на органах, локализующихся в малом тазу;
- страдающим от бесплодия (особенно при отсутствии причины);
- имеющим в анамнезе более двух случаев не вынашивания беременности или случай мертворождения;
- в которых диагностированы другие виды инфекций с половым путем передачи (например, хламидиоз, трихомониаз, гонорея).
Откуда и когда берется биоматериал
Проведения бакпасева осуществляется только в случае диагностирования определенного патологического процесса в органах мочеполовой сферы. Данное обследование, а также ряд других анализов (например, анализ мочи) могут проводиться с профилактической целью.
При обнаружении уреаплазмоза и прохождении курса лечения повторное обследование рекомендуется делать через две недели после окончания приема лекарственных препаратов.
Забор биологического материала у мужчин осуществляют проведением взятия соскоба со слизистой органов мочевыводного канала, материалом может быть также сперма.
У представительниц слабой половины человечества материал берут после окончания менструации с уретры, канала шейки матки и свода влагалища.
Обратите внимание, в подавляющем большинстве случаев повторный забор материала проводится мужчинам один раз, а представительницам слабой половины человечества трижды (до и после менструации).
Посев на уреаплазменную инфекцию проводится:
- для определения причины формирования воспалительных процессов органов мочеполовой сферы, имеющих хроническое течение;
- для дифференциальной диагностики болезней, имеющих похожую симптоматику;
- для определения чувствительности возбудителя ко всем антибиотикам
- с профилактической целью.
Читайте также по теме
Правила подготовки к обследованию
Чтобы результаты проведенного посева на уреаплазму парвум были точнее, необходимо особое внимание обратить на подготовку к сдаче анализа. Рекомендуется:
- Воздерживаться от мочеиспускания в течение нескольких часов до проведения анализа.
- Избегать половых отношений за 24 часа до дня сдачи анализа.
- Прекратить употребление любых медикаментозных средств, особенно антибактериальных препаратов, противогрибковых и антисептиков. Если же осуществить это нет возможности, то об этом нужно в обязательном порядке сказать врачу, проводящему обследование.
- Представительницам слабой половины человечества забор материала проводится через семь дней после менструации.
При осуществлении комплексного бакпосева на уреаплазму и микоплазму нужно осуществить забор большого объема материала. Его берут с уретры мужчин и внутренних стенок влагалища у женщин. Если у представителей сильной половины человечества диагностируется урогенитальная инфекция, им необходимо дополнительно провести анализ мочи.
Довольно часто заболевшие люди интересуются вопросом, как микроорганизмы попадают в человеческий организм. Ответ довольно прост, уреаплазмы считаются условно-патогенными микроорганизмами, они присутствуют в организме человека все время. Развитие патологического процесса наблюдается, если появляются способствующие факторы: заболевания половой сферы, психологические и эмоциональные перегрузки, приводящие к снижению сопротивляемости организма. Происходит активизация микроорганизмов и повышение проницаемости слизистой органов мочеполовой сферы. Наличие незначительного количества уреаплазм, которое считается нормой, не приводит к формированию патологического состояния.
Оценка результатов
В условиях современности исследование позволяет определить точные показатели уреаплазмы, а также резистентность к медикаментозным препаратам.
Если количество возбудителя болезни не больше 10 в 4 степени КОЕ на 1 мл., это норма и процесс воспалительного характера обычно не развивается. Человек считается носителем, а микроорганизмы не оказывают отрицательного воздействия на его организм. Если же их число выше, это указывает на наличие активной инфекции.
Отрицательным считается результат, при котором наблюдается отсутствие роста колоний на питательной среде.
Обратите внимание, говорить о заболеваниях оценив только результаты исследования, нельзя, ведь должен еще и осуществляться общий и инструментальный осмотр пациента. Расшифровка анализа проводится только доктором.
Точными нельзя считать результаты анализа на чувствительность к антибиотикам. Объясняется это тем, что в жизни уреаплазма может вести себя совершенно по-другому, чем в созданных искусственно лабораторных условиях.
Посев может показать недостоверную информацию, бывает это в случае перехода уреаплазм в персистентное состояние, бактерии теряют способность к процессу размножения на питательной среде.
Похожей ситуация может быть при приеме антибактериальных препаратов или осуществлении неадекватного лечения патологического состояния. Микроорганизмы локализуются в клетках эпителия слизистой, и антибиотики не способны оказывать на них своего пагубного влияния. Оптимальным вариантом при этом считается проведение контрольного обследования, особенно после прохождения курса лечения. Это позволит определить уровень эффективности проводимой терапии.
Алгоритм действий при получении положительного результата посева
В случае обнаружения уреаплазменной инфекции в организме дальнейшая тактика в основном зависит от общего состояния человека. Назначение медикаментозной терапии считается оправданным, если наблюдается присутствие процесса воспалительного характера, имеются жалобы и патологические симптомы.
Не зависимо от случая, необходимо обратиться за консультацией к врачу, который проведет уточнение диагноза и назначит адекватную схему лечения. Вспомогательным будет проведение посева для определения того, к каким средствам с антибактериальным эффектом микроорганизм устойчив.
В настоящее время существует множество современных способов выявления различных урогенитальных инфекций. Посев на уреаплазму является достаточно эффективным методом выявления бактериальной инфекции как у мужчин, так и у женщин. Для выявления уреаплазмы материал для исследований берется в стерильных условиях и только квалифицированными специалистами. Это обязательные требования относятся почти ко всем видам сбора анализов на посевы в области гинекологии и урологии с целью точного определения наличия инфекции.
Бактериологический (бак) посев является культуральным методом диагностики. Для его проведения требуется специальная питательная среда, в которую помещают тот или иной биологический материал. В зависимости от показаний к такому материалу относятся все жидкие среды организма, а в данном случае выделяемые из урогенитального тракта. Но есть исключения, например, посев на уреаплазму мочи собирается только у мужчин. Бактериологический посев считается достаточно информативным методом исследования, единственный его недостаток заключается в длительности высевания бактерий. Поэтому сейчас популярно сдавать урогенитальный соскоб для диагностики методом полимерной цепной реакции (ПЦР).
Что такое уреаплазма и особенности ее выявления
Уреаплазма — это микроорганизм, который вызывает заболевание уреаплазмоз и является причиной возникновения воспалительных процессов в мочеполовой системе. Эта инфекция передается половым путем. Обнаружить его возможно только при проведении лабораторных исследований. Считается, что женский организм наиболее восприимчив к хламидиям, чем к уреаплазме, и им практически всегда назначают дополнительный бактериологический посев на хламидии. Современные методы диагностики позволяют выявить не только наличие инфекции, но и ее количество. Если количественная норма инфекции не завышена, то проводится только иммуномодулирующая терапия.
Посев на уреаплазму, как правило, делается для определения наличия уже самой инфекции по показаниям. А для определения наличия антител в организме, выработанных ранее к данной инфекции, требуется анализ крови. Очень важно определить количество микроорганизмов уреаплазмы, которое попало в организм. При попадании инфекции в большом количестве иммунная реакция существенно снижается. Поэтому при любом контакте с больным уреаплазмозом партнере необходимо обратиться к гинекологу или урологу для консультации. Чтобы исследование было полным лучше проводить комплексную диагностику на несколько урогенитальных инфекций, в том числе посев на микоплазму и хламидии.
Правила подготовки к посеву на уреаплазму
Для проведения эффективной лабораторной диагностики на выявление уреаплазмы необходимо соблюдать общие правила подготовки до сбора биологического материала. К таким правилам относятся:
- ограничение в употреблении антибиотиков, антисептических и противогрибковых препаратов до проведения анализа;
- воздержание от мочеиспускания за 2-3 часа до проведения анализа;
- сбор материала не ранее чем на 7 день начала менструального цикла.
Помимо основных правил, существует ряд предписаний для гинекологов и урологов по сбору материала для подобных исследований. Они различаются в зависимости от требуемого биологического материала. Это могут быть выделения из уретры, вульвы, посев из влагалища и его преддверия, шейки матки и т.д. Если посев комплексный, например, одновременно на уреаплазму и микоплазму, то требуется довольно большое количество исследуемого материала. Также для полноты исследования урогенитальных инфекций у мужчин, для проведения посева требуется сбор мочи.
Бактериологический посев и чувствительность к антибиотикам
В современной медицинской практике врачи, направляя пациента на бактериологический посев на микоплазму, уреаплазму и хламидии, рекомендуют делать дополнительное исследование — антибиотикограмму. Таким образом определяется чувствительность к антибиотикам тех или иных микроорганизмов. Люди, которые предпочитают делать подобные анализы в частных (платных) лабораториях, нередко ссылаются на то, что это лишь пустая трата денег. И это огромное заблуждение, ведь речь идет о довольно серьезных заболеваниях, в первую очередь влияющих на репродуктивную функцию женщин и мужчин.
На самом деле в современное время из-за массового потребления антибиотиков чувствительность к подобным препаратам значительно снижена. В научной среде существует такая теория, что в скором времени человечество может утратить способность исцеляться с помощью антибиотиков. А ведь не так давно их открытие сделало прорыв в медицине. К тому же такие заболевания, как уреаплазмоз, хламидиоз и микоплазмоз, вылечить окончательно невозможно. Поэтому посев на уреаплазму для назначения эффективного лечения лучше сдавать с проверкой на чувствительность к антибиотикам, так же как посев на микоплазму и хламидии.